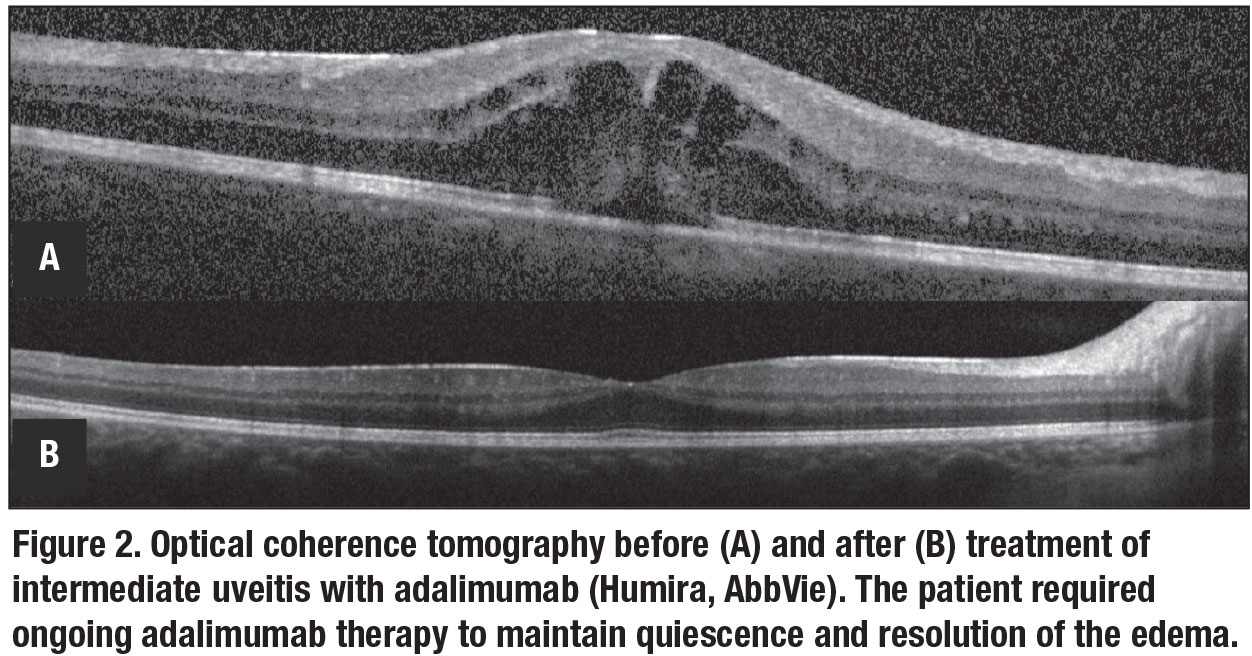

|
The uveitides, particularly of the posterior segment, are a collection of diseases with the potential for permanent vision loss without careful control of intraocular inflammation. The systemic treatments available continue to expand, particularly with the ongoing development of biologic and small molecule inhibitor therapies. Here, we review the indications for pursuing systemic therapy, conventional immunosuppressants and biologic agents, along with future treatments under investigation.
When to consider systemic therapy
Systemic immunosuppression is frequently managed in conjunction with a rheumatologist. The patient and the treating ophthalmologist and rheumatologist must collaborate on a decision to proceed with a systemic agent. In cases with an active systemic autoimmune disease in which uveitis is one of several manifestations, the underlying condition will frequently direct the choice of therapeutic agent.
Consider systemic corticosteroids for uveitis in the following three scenarios:
- when other treatments fail to control the uveitis;
- in cases that require frequent or ongoing short-acting periocular or intravitreal steroid injections (to avoid “sawtooth decline”); and
- in pediatric patients who need frequent topical steroids.
A systemic approach may also be preferred in patients with known intraocular pressure steroid responses or those with bilateral disease.
Follow-up data from the Multicenter Uveitis Steroid Treatment (MUST) trial found systemic corticosteroids and immunosuppression yielded better visual acuity at seven years than a long-acting local corticosteroid implant (fluocinolone acetonide 0.59 mg).1 Systemic adverse outcomes were similar between the treatment groups except when more frequent infections required treatment in the immunosuppression arm.1 The goal of steroid-sparing therapy is to control ocular inflammation while allowing for taper of systemic corticosteroids to <7.5 mg daily, with complete taper off systemic corticosteroids being ideal.
 |
Conventional immunosuppressants
Conventional immunosuppressants consist of three classes (Table, page 12): antimetabolites (methotrexate, mycophenolate, azathioprine); calcineurin inhibitors (cyclosporine, tacrolimus); and alkylating agents (cyclophosphamide and chlorambucil). Many physicians prefer methotrexate and mycophenolate as initial steroid-sparing therapies because they have fewer side effects than azathioprine.
However, azathioprine is often used in women with plans for childbearing due to the teratogenic potential of methotrexate and mycophenolate. In the Systemic Immunosuppressive Therapy for Eye Diseases (SITE) cohort, methotrexate, mycophenolate and azathioprine therapy resulted in control of uveitis with a corticosteroid sparing effect in 58, 55 and 47 percent of subjects, respectively, within a year of therapy (Figure 1, page 11).2-4
The First-line Antimetabolites as Steroid-sparing Treatment (FAST) trial recently compared oral methotrexate 25 mg weekly with mycophenolate mofetil 3 g daily in a randomized fashion for noninfectious intermediate, posterior and panuveitis. The study found methotrexate to be noninferior to mycophenolate in controlling uveitis with a corticosteroid-sparing effect by six months of treatment.5 Either methotrexate or mycophenolate is a reasonable first-line agent in patients requiring a steroid-sparing treatment. The individual patient’s social and medical history and personal preferences should play a role in the agent selected.
Calcineurin inhibitors are most commonly used in conjunction with an antimetabolite in cases where antimetabolite monotherapy is inadequate to control uveitis. Now many physicians will escalate therapy to a biologic agent, most commonly a tumor necrosis factor (TNF) inhibitor, rather than adding a calcineurin inhibitor.
Due to the associated risk for malignancies, alkylating agents are typically reserved for severe, recalcitrant cases of uveitis, although they have the potential to induce remission.6 All conventional immunosuppressants carry an increased risk for infection and require routine monitoring of blood counts and hepatic and renal function for toxicity.
 |
Biologic treatments
Biologic therapies, engineered proteins that target specific immune molecules, are becoming increasingly important in treating severe uveitis. The most used class, TNF inhibitors, consists of five agents:
- adalimumab (Humira, AbbVie);
- infliximab (Remicade, Janssen);
- certolizumab (Cimzia, UCB);
- golimumab (Simponi, Janssen); and
- etanercept (Enbrel, Amgen).
TNF inhibitors require baseline screening for tuberculosis and hepatitis, and should be avoided in patients with known demyelinating disorders (Table).
The Food and Drug Administration approved adalimumab, administered subcutaneously, in 2016 for treatment of noninfectious intermediate, posterior and panuveitis. Clinical trials demonstrated adalimumab increased time to treatment failure in both active and corticosteroid-dependent inactive uveitis after systemic corticosteroid taper (Figure 2).7,8 A trial also found adalimumab effective for juvenile idiopathic arthritis uveitis incompletely controlled with methotrexate.9
Infliximab, another TNF inhibitor administered intravenously, also shows significant evidence for efficacy in treating uveitis. Golimumab and certolizumab have been used successfully in some cases of uveitis refractory to other TNF inhibitors. Etanercept is less effective in controlling ocular inflammation and isn’t recommended for management of uveitis.
|
Anti-IL6 receptor
 |
Inhibition of the interleukin-6 signaling pathway has shown efficacy in treating intermediate, posterior and panuveitis in two small clinical trials of tocilizumab10 and sarilumab.11 A retrospective case series of tocilizumab (Actemra, Roche/Genentech) demonstrated efficacy in treating refractory uveitic macular edema in patients with a history of failing TNF inhibitor therapy.12 As with other biologic therapies, anti-IL6 therapy carries an increased risk for
infection; the use of this class of drug requires monitoring for cytopenias and transaminitis (Table).
Future therapies
New systemic therapeutics continue to be investigated for use in uveitis. Randomized clinical trials to assess the efficacy of Janus kinase inhibitors are being conducted in intermediate, posterior and panuveitis (NCT03207815) and in juvenile ideopathic arthritis-associated uveitis (NCT04088409). Continued efforts are also being made to compare the effectiveness of agents already available, including a randomized controlled trial comparing the effectiveness of adalimumab vs. conventional agents in corticosteroid sparing inflammation control of noninfectious intermediate, posterior and panuveitis (NCT03828019).13
Bottom line
Systemic immunosuppression remains a mainstay in the management of uveitis, particularly to avoid patient exposure to long-term corticosteroids. Many patients will require therapy with more than one agent to control their disease. Collaboration and close communication with rheumatology colleagues are key in selecting an appropriate therapeutic regimen, in determining how patients respond to and tolerate the medications, and in ensuring treatment advances in persistent cases. RS
REFERENCES
1. Kempen JH, Altaweel MM, Holbrook JT, Sugar EA, Thorne JE, Jabs DA. Association between long-lasting intravitreous fluocinolone acetonide implant vs systemic anti-inflammatory therapy and visual acuity at 7 years among patients with intermediate, posterior, or panuveitis. JAMA, 2017;317:1993-2005.
2. Gangaputra S, Newcomb CW, Liesegang TL, et al. Methotrexate for ocular inflammatory diseases. Ophthalmology. 2009;116:2188-2198.e1.
3. Daniel E, Thorne JE, Newcomb CW, et al. Mycophenolate mofetil for ocular inflammation. Am J Ophthalmol. 2010;149:423-432.e1-2.
4. Pasadhika S, Kempen JH, Newcomb CW, et al. Azathioprine for ocular inflammatory diseases. Am J Ophthalmol. 2009;148:500-509.e2.
5. Rathinam SR, Gonzales JA, Thundikandy R, et al. Effect of Corticosteroid-sparing treatment with mycophenolate mofetil vs methotrexate on inflammation in patients with uveitis: A randomized clinical trial. JAMA. 2019;322:936-945.
6. Pujari SS, Kempen JH, Newcomb CW, et al. Cyclophosphamide for ocular inflammatory diseases. Ophthalmology. 2010;117:356-365.
7. Jaffe GJ, Dick AD, Brezin AP, et al. Adalimumab in patients with active noninfectious uveitis. N Engl J Med. 2016;375:932-43.
8. Nguyen QD, Merrill PT, Jaffe GJ, et al. Adalimumab for prevention of uveitic flare in patients with inactive non-infectious uveitis controlled by corticosteroids (VISUAL II): a multicentre, double-masked, randomised, placebo-controlled Phase 3 trial. Lancet. 2016;388:1183-1192.
9. Ramanan AV, Dick AD, Jones AP, et al. Adalimumab plus methotrexate for uveitis in juvenile idiopathic arthritis. N Engl J Med. 2017;376:1637-1646.
10. Sepah YJ, Sadiq MA, Chu DS, et al. Primary (month-6) outcomes of the STOP-Uveitis Study: Evaluating the safety, tolerability, and efficacy of tocilizumab in patients with noninfectious uveitis. Am J Ophthalmol. 2017;183:71-80.
11. Heissigerova J, Callanan D, de Smet MD, et al. Efficacy and Safety of sarilumab for the treatment of posterior segment noninfectious uveitis (SARIL-NIU): The Phase 2 SATURN Study. Ophthalmology. 2019;126:428-437.
12. Vegas-Revenga N, Calvo-Rio V, Mesquida M, et al. Anti-IL6-receptor tocilizumab in refractory and noninfectious uveitic cystoid macular edema: multicenter study of 25 patients. Am J Ophthalmol. 2019;200:85-94.
13. U.S. National Library of Medicine. www.clinicaltrials.gov. Accessed December 15, 2019.




